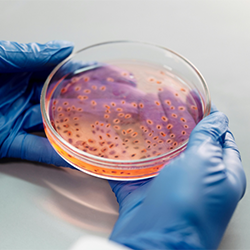

Portafolio de tecnologías

Análogos retroinversos de la angiotensina-(1-9) para el tratamiento de enfermedades cardiovasculares
Composiciones farmacéuticas para inducir efectos cardioprotectores y antirremodelantes y un método para tratar enfermedades cardiovasculares, renales y cerebrales utilizando péptidos retroinversos.

Ánodos compuestos de grafeno-litio altamente conductores para el futuro de los sectores de la electromovilidad y la energía
Novedoso proceso de fabricación y materiales innovadores con conductividad eléctrica mejorada para ánodos en baterías de iones de litio.

BlueRemin: remineralización dental avanzada y prevención de la caries
Las caries dentales y la desmineralización comprometen la salud bucodental en todo el mundo. BlueRemin, una novedosa formulación, ofrece una solución integral al combinar una remineralización eficaz con una acción antimicrobiana específica.

Celda de flotación
Nueva celda de flotación por espuma que combina los efectos centrífugo y magnético, reduciendo significativamente el uso de agua en la minería del cobre.

Ciruela "Sweet Pekeetah"
Nueva variedad de ciruela asiática (Prunussalicina).

Extracción directa de litio con membranas para su uso en salares
Novedoso proceso para obtener cristales de litio de alta pureza y concentración a partir de salmueras de baja concentración obteniendo también agua dulce para su reutilización en plantas.

Formulación de una nueva vacuna contra Escherichia coli productora de toxina Shiga (STEC) y su aplicación en animales
Vacuna recombinante basada en proteínas quiméricas, destinada a prevenir las infecciones causadas por Escherichia coli productora de toxina Shiga (STEC) en el ganado y que ofrece una alternativa innovadora de amplio espectro dirigida a serogrupos relevantes.

Herramienta de IA para la persecución de delitos
Sistema integrado de análisis de información basado en inteligencia artificial para investigar delitos contra la propiedad, que admite información no estructurada.

Kiwi "Lihuen"
Nueva variedad amarilla de kiwi.

Método para la eliminación y degradación de colorantes de efluentes textiles
Nuevo método para preparar nanocompuestos orgánico-inorgánicos de hidróxido de zinc laminar para su uso en la eliminación y degradación de colorantes de efluentes textiles.

Navegación autónoma y teleoperada en faenas a cielo abierto
Conjunto de herramientas que permite la navegación autónoma y asiste la teleoperada de vehículos en espacios cerrados y abiertos, incluidos túneles, cuevas e instalaciones.

Navegación autónoma y teleoperada en faenas subterráneas
Nuevo sistema para la navegación y operación autónoma de vehículos dentro de entornos subterráneos, como túneles, explotaciones mineras, construcción, excavaciones profundas, entre otros.

Nuevo anticuerpo monoclonal terapéutico y fragmentos anti-MICA para el tratamiento del cáncer
Anticuerpo humano recombinante y un fragmento capaz de neutralizar la proteína soluble MICA y opsonizar células tumorales, para el tratamiento de varios tipos de cáncer.
Nuevos antibióticos quinónicos contra bacterias farmacorresistentes
Nueva familia de antibióticos con actividad frente a bacterias gran positivas multirresistentes.

PVC funcionalizado con biomoléculas
Nuevo material capaz de reducir el uso de plastificantes en el PVC, como el DEHP que ha sido descrito como altamente tóxico y perjudicial para la salud humana.

Realidad aumentada - localizador de dispositivos inalámbricos
Dispositivo capaz de detectar y localizar fuentes electromagnéticas como teléfonos móviles, superponiendo la información en la pantalla de una cámara. De gran utilidad para la localización de personas, la seguridad y el control de fronteras y aeropuertos.

Sistema de comunicaciones electrónicas seguras mediante HSM basado en criptografía umbral
Sistema distribuido que utiliza criptografía umbral capaz de simular un HSM sin hardware costoso y manteniendo una alta seguridad.

Sistema de expresión de alta eficiencia para la producción de proteínas recombinantes en células CHO
Sistema de expresión mejorado que permite la producción de proteínas recombinantes/anticuerpos en células CHO 4,5 veces más eficiente que los vectores comerciales disponibles.

Terapia celular contra la mastitis bovina usando células madre mesenquimales (MSC)
Tecnología de medicina regenerativa, basada en una composición de células madre mesenquimales alogénicas (MSC) de origen bovino y su uso en mastitis para el cuidado de animales lecheros.

Terapia génica AAV/IGF-2 para el tratamiento de la enfermedad de Huntington y otras enfermedades por mal plegamiento de proteínas
Terapia génica que recupera y mejora el deterioro neuronal que se produce en la enfermedad de Huntington y otras enfermedades por mal plegamiento de proteínas.

UDESS 2.0 - Un robusto software de planificación
Planificador de tareas que incorpora un amplio conjunto de variables, tales como dependencias de tareas, costes y beneficios, y disponibilidad de recursos. Orienta la planificación a la maximización de una función objetivo.

Vacuna subunitaria polivalente contra mastitis bovina
Vacuna subunitaria, polivalente y altamente inmunogénica para la prevención de la mastitis bovina, capaz de proteger contra los principales patógenos responsables de esta enfermedad y reducir significativamente la necesidad del uso de antibióticos en la industria lechera.

